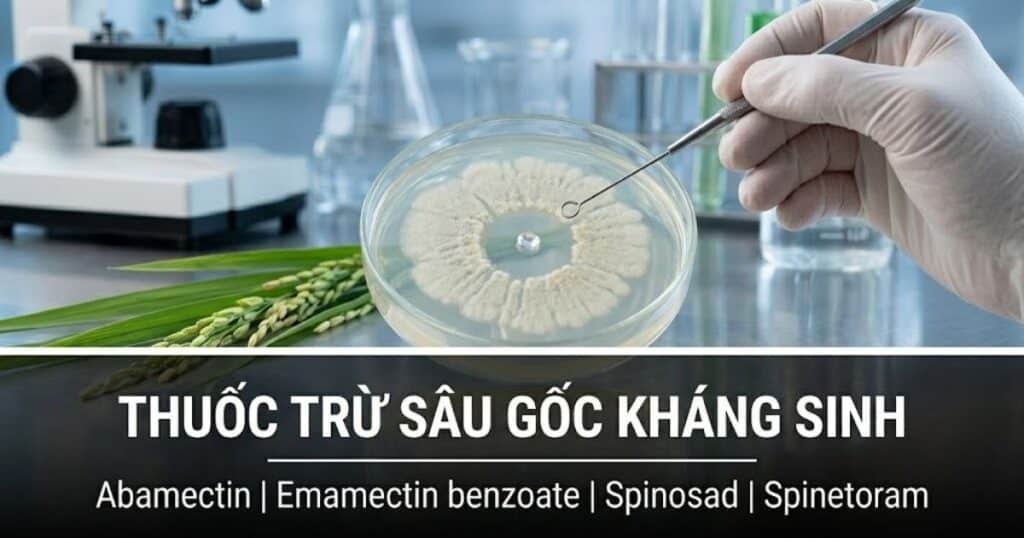
Thuốc trừ sâu gốc kháng sinh

Trong nhóm thuốc trừ sâu sinh học, nhiều người thường chỉ nghĩ đến các chế phẩm chứa vi sinh vật sống như nấm, vi khuẩn hoặc virus. Tuy nhiên, trong thực tế bảo vệ thực vật còn có một nhóm rất quan trọng khác, đó là thuốc trừ sâu có nguồn gốc kháng sinh. Đây là nhóm hoạt chất không chứa vi sinh vật sống, nhưng lại được tạo ra từ các chất chuyển hóa sinh học do vi sinh vật đất tiết ra trong quá trình phát triển.
Chính vì mang nguồn gốc sinh học nhưng được tinh chế thành hoạt chất ổn định, nhóm thuốc này có một vị trí rất đặc biệt. Nó không “mềm” theo kiểu vi sinh sống, nhưng cũng không hoàn toàn giống các nhóm hóa học tổng hợp cổ điển. Trong nhiều trường hợp, thuốc gốc kháng sinh cho hiệu lực rất mạnh, liều dùng rất thấp, đặc biệt hữu ích với các đối tượng khó trị như nhện đỏ, bọ trĩ, sâu vẽ bùa, sâu tơ và sâu bộ cánh vẩy.
Tuy nhiên, đây cũng là nhóm dễ bị lạm dụng ngoài thực tế. Vì hiệu quả nhìn thấy khá rõ, nhiều nhà vườn có xu hướng dùng lặp đi lặp lại một hoạt chất quen thuộc, nhất là Abamectin. Kết quả là sau một thời gian, quần thể nhện đỏ hoặc bọ trĩ giảm nhạy rất nhanh. Do đó, muốn sử dụng đúng nhóm thuốc này, cần hiểu rõ bản chất của nó, hiểu đúng từng nhóm hoạt chất và đặc biệt phải nắm chắc nguyên tắc luân phiên.
Thuốc trừ sâu gốc kháng sinh là gì?
Thuốc trừ sâu gốc kháng sinh là nhóm hoạt chất được chiết xuất hoặc phát triển từ các chất chuyển hóa thứ cấp do vi sinh vật đất tạo ra trong quá trình sinh trưởng. Những vi sinh vật này, chủ yếu thuộc nhóm xạ khuẩn, tiết ra các hợp chất có hoạt tính sinh học để cạnh tranh với các sinh vật khác trong môi trường sống. Con người khai thác chính những hợp chất đó, sau đó tinh chế và bào chế thành thuốc trừ sâu dùng trong nông nghiệp.
Điều cần nhấn mạnh là đây không phải thuốc vi sinh sống. Thuốc không chứa bào tử, không cần vi sinh vật sống tiếp tục phát triển ngoài đồng ruộng mới có tác dụng. Vì vậy, nhóm này không phụ thuộc vào độ ẩm theo kiểu nấm ký sinh côn trùng, cũng không nhạy cảm với điều kiện môi trường theo cách mà nhiều chế phẩm vi sinh sống gặp phải.
Chính đặc điểm đó tạo ra một lợi thế rất rõ. Thuốc gốc kháng sinh giữ được bản chất sinh học ở nguồn gốc hoạt chất, nhưng khi đưa ra thực tế sử dụng lại có tính ổn định và hiệu lực gần với một hoạt chất hóa học hiện đại.
Bản chất giao thoa giữa sinh học và hóa học
Nhóm thuốc này có thể xem là cầu nối giữa hai thế giới. Một mặt, hoạt chất của nó có nguồn gốc từ quá trình lên men vi sinh. Mặt khác, sau khi được tinh chế và thương mại hóa, nó hoạt động như một hoạt chất trừ sâu thực thụ với liều lượng rất nhỏ, hiệu lực cao và đòi hỏi quản lý kháng thuốc nghiêm ngặt.
Đây là lý do ngoài thực tế nhiều người gọi nhóm này là “sinh học mạnh”. Cách gọi này dễ hiểu về mặt cảm nhận, nhưng nếu viết đúng về kỹ thuật thì nên gọi là thuốc trừ sâu có nguồn gốc kháng sinh hoặc thuốc sinh học có nguồn gốc từ quá trình lên men vi sinh.
Điểm mạnh nổi bật của nhóm này là:
- Hoạt lực cao ở liều lượng thấp
- Thường có tính thấm sâu tốt ở một số hoạt chất
- Phù hợp với nhiều chương trình canh tác cần kiểm soát dư lượng
- Có giá trị lớn trong xử lý các đối tượng nhỏ, khó trị, sống khuất trong lá
Tuy nhiên, điểm yếu cũng rất rõ:
- Nguy cơ kháng thuốc cao nếu dùng lặp lại
- Một số hoạt chất rất độc với ong khi thuốc chưa khô
- Rủi ro đáng kể với cá và sinh vật thủy sinh
Vì vậy, không thể chỉ nhìn nhóm này dưới góc độ “sinh học nên an toàn”, mà phải nhìn như một nhóm hoạt chất mạnh, cần dùng đúng như bất kỳ nhóm quan trọng nào trong bảo vệ thực vật.
Hai nhóm hoạt chất chính của thuốc trừ sâu gốc kháng sinh
Trong thực tế, thuốc trừ sâu nguồn gốc kháng sinh hiện diện nổi bật nhất ở hai nhánh lớn: Avermectins và Spinosyns. Đây là hai nhóm mà hầu như bất kỳ người làm nông nghiệp nào cũng đã từng gặp hoặc từng sử dụng.
Nhóm Avermectins
Đây là nhóm rất quen thuộc ngoài thị trường, được chiết xuất từ quá trình lên men của một chủng xạ khuẩn đất. Trong thực tế sử dụng, nhóm này nổi tiếng nhờ khả năng xử lý tốt nhện đỏ, bọ trĩ, dòi đục lá và nhiều đối tượng nhỏ sống khuất trong mô lá.
Abamectin
Abamectin là hoạt chất phổ biến nhất của nhóm này. Trong rất nhiều hệ cây trồng, đây là hoạt chất gần như được xem là lựa chọn quen thuộc khi gặp:
- Nhện đỏ
- Bọ trĩ
- Dòi đục lá
- Sâu vẽ bùa
- Một số sâu nhỏ gây hại ngoài lá
Giá trị lớn nhất của Abamectin nằm ở khả năng thấm sâu vào phiến lá. Khi phun lên bề mặt lá, hoạt chất không đi khắp cây như thuốc lưu dẫn, nhưng lại có thể xuyên qua lớp biểu bì và đi vào mô lá. Chính nhờ đặc điểm đó, nó rất mạnh với những đối tượng đang sống ở mặt dưới lá hoặc ăn bên trong lớp mô lá.
Trong thực tế, Abamectin đặc biệt được ưa dùng trên:
- Sầu riêng
- Mãng cầu xiêm
- Dưa lưới
- Cà chua
- Cây có múi
- Một số cây hoa và rau màu có áp lực nhện, bọ trĩ cao
Tuy nhiên, đây cũng là hoạt chất bị lạm dụng nhiều nhất. Vì dùng quá phổ biến, nguy cơ kháng thuốc trên nhện đỏ và bọ trĩ là rất cao nếu nhà vườn cứ lặp lại liên tục qua nhiều lứa.
Emamectin benzoate
Emamectin benzoate là một dẫn xuất bán tổng hợp của nhóm avermectin, được phát triển theo hướng tăng hiệu lực trên sâu miệng nhai, đặc biệt là sâu bộ cánh vẩy.
Trong thực tế, hoạt chất này nổi bật với:
- Sâu khoang
- Sâu xanh
- Sâu tơ
- Sâu cuốn lá
- Nhiều sâu ăn lá trên rau màu, bắp, cây ăn trái
So với Abamectin, Emamectin benzoate được biết đến nhiều hơn với vai trò trị sâu bộ cánh vẩy. Đây là lý do người làm nông thường thấy hoạt chất này xuất hiện trong các công thức trị sâu tơ, sâu xanh, sâu khoang trên rau màu hoặc sâu ăn lá trên cây công nghiệp.
Tuy nhiên, cần nhớ rất rõ một điểm: Abamectin và Emamectin benzoate cùng thuộc một nhóm cơ chế tác động. Vì vậy, không thể xem chúng là hai bước luân phiên độc lập. Nếu quần thể sâu hoặc nhện đã giảm nhạy với một hoạt chất, việc đổi sang hoạt chất còn lại chưa chắc mang lại khác biệt đủ lớn về mặt quản lý kháng thuốc.
Nhóm Spinosyns
Đây là nhóm hoạt chất được tạo ra từ quá trình lên men của một loài vi sinh vật đất khác. Trong thực tế sản xuất, nhóm này thường được xem là nhánh cao cấp hơn về mặt định vị thị trường, vì có hiệu lực tốt trên bọ trĩ, sâu tơ, dòi đục lá và nhiều đối tượng khó trị, đồng thời phù hợp hơn với một số chương trình canh tác an toàn.
Spinosad
Spinosad là hoạt chất nổi bật nhất của nhóm này. Trong thực tế, Spinosad thường được dùng với:
- Bọ trĩ
- Sâu tơ
- Dòi đục lá
- Một số sâu ăn lá nhỏ
- Một số côn trùng hại rau màu và cây ăn trái
Giá trị của Spinosad nằm ở chỗ vừa có hiệu lực tốt, vừa thường được người làm kỹ thuật đánh giá cao hơn về tính chọn lọc so với nhiều nhóm phổ rộng cũ.
Spinetoram
Spinetoram là hoạt chất phát triển tiếp theo trong cùng nhóm, thường cho hiệu lực mạnh hơn trên một số đối tượng, đặc biệt là bọ trĩ và sâu bộ cánh vẩy khó trị.
Trong thực tế, đây là hoạt chất được dùng nhiều khi:
- Bọ trĩ gây áp lực lớn trên dưa lưới, cà chua, ớt
- Sâu tơ đã có dấu hiệu giảm nhạy với nhiều nhóm cũ
- Cần một hoạt chất mạnh nhưng vẫn muốn giữ định hướng canh tác an toàn hơn
Tuy nhiên, cũng như nhóm Avermectins, Spinosad và Spinetoram không phải là hai bước luân phiên hoàn toàn độc lập, vì chúng vẫn nằm trong cùng một nhóm cơ chế tác động.
Cơ chế tác động của thuốc gốc kháng sinh
Tác động lên hệ thần kinh
Với nhóm Avermectins, cơ chế nổi bật nhất là tác động lên các kênh ion chloride trong hệ thần kinh côn trùng. Khi hoạt chất gắn vào vị trí đích, hệ thần kinh bị ức chế mạnh, làm côn trùng:
- Ngừng ăn
- Giảm vận động
- Tê liệt dần
- Chết sau đó
Điểm cần hiểu đúng là nhiều đối tượng không rơi chết ngay sau vài phút như với thuốc tiếp xúc thần kinh mạnh. Dấu hiệu sớm hơn thường là ngừng ăn và giảm hoạt động, sau đó mới chuyển sang chết hoàn toàn trong khoảng một đến vài ngày.
Tính thấm sâu của nhóm Avermectins
Đây là một trong những “điểm ăn tiền” nhất của nhóm hoạt chất này. Khi phun lên lá, Abamectin và ở mức độ nhất định là Emamectin không đi dọc thân cây như thuốc lưu dẫn, nhưng lại có khả năng xuyên qua lớp biểu bì để đi vào mô lá.
Chính vì vậy, nhóm này rất mạnh với:
- Nhện đỏ trú mặt dưới lá
- Bọ trĩ nấp trong kẽ lá
- Dòi đục lá ăn trong mô
- Sâu vẽ bùa gây hại bên trong lớp biểu bì
Đây là một lợi thế kỹ thuật rất lớn, vì nó giúp hoạt chất ít bị rửa trôi hơn sau khi đã thấm vào lá, đồng thời bền hơn so với những thuốc chỉ nằm ngoài bề mặt.
Ưu điểm của thuốc trừ sâu gốc kháng sinh
Liều lượng sử dụng rất thấp
Đây là một ưu điểm nổi bật. Nhóm thuốc này thường cho hiệu quả cao ngay ở liều lượng hoạt chất thấp. Điều đó giúp giảm lượng hoạt chất phải đưa ra môi trường nếu sử dụng đúng cách.
Thích hợp trong chương trình quản lý dư lượng
Do hoạt chất mạnh ở liều thấp và một số loại bị phân hủy khá nhanh trên bề mặt dưới tác động của ánh sáng, nhóm thuốc này thường được dùng trong nhiều chương trình canh tác cần kiểm soát tốt dư lượng.
Tuy nhiên, cách viết đúng cần là thời gian cách ly phụ thuộc vào từng hoạt chất, từng cây trồng và từng sản phẩm đăng ký, chứ không nên tuyệt đối hóa rằng mọi thuốc gốc kháng sinh đều giống nhau.
Hiệu quả tốt trên những đối tượng khó trị
Đây là giá trị thực tiễn lớn nhất của nhóm này. Trong nhiều trường hợp, nhện đỏ, bọ trĩ, sâu vẽ bùa, dòi đục lá hoặc sâu tơ là những đối tượng rất khó xử lý bằng thuốc tiếp xúc đơn thuần. Thuốc gốc kháng sinh, đặc biệt là nhóm Avermectins và Spinosyns, lấp rất tốt khoảng trống này.
Sau khi đã thấm vào lá, hiệu lực ổn định hơn trước mưa
Với các hoạt chất có tính thấm sâu, khi đã đi vào mô lá, nguy cơ bị rửa trôi bởi mưa sẽ giảm đi đáng kể. Đây là một lợi thế kỹ thuật rõ ràng trong điều kiện thời tiết không ổn định.

Rủi ro và những điểm cần đặc biệt lưu ý
Nguy cơ kháng thuốc rất cao
Đây là điểm quan trọng nhất. Nhện đỏ và bọ trĩ là hai nhóm có tốc độ nhân quần thể rất nhanh. Nếu cứ lặp lại Abamectin hoặc một hoạt chất cùng nhóm qua nhiều lứa liên tiếp, nguy cơ giảm nhạy sẽ xảy ra rất nhanh. Khi đó, người dùng thường có cảm giác “thuốc đang mạnh bỗng dưng yếu đi”, nhưng thực chất là quần thể dịch hại đã thích nghi dần với áp lực hoạt chất.
Vì vậy, thuốc gốc kháng sinh không được phép dùng theo thói quen.
Độc với ong khi dung dịch còn ướt
Dù là nhóm có nguồn gốc sinh học, điều đó không có nghĩa là vô hại với mọi sinh vật có ích. Một số hoạt chất trong nhóm này có thể rất nguy hiểm với ong nếu ong tiếp xúc với dung dịch thuốc khi chưa khô.
Do đó, nguyên tắc cơ bản vẫn là:
- Không phun khi cây đang ra hoa mạnh nếu có nguy cơ ong hoạt động
- Không phun vào thời điểm ong đang làm việc nhiều trên vườn
- Tránh xem nhẹ cảnh báo sinh thái chỉ vì thuốc mang gốc “sinh học”
Rất nguy hiểm với thủy sinh vật
Đây là điểm cần nhấn mạnh thật rõ. Nhóm Avermectins đặc biệt đáng lưu ý với cá và sinh vật thủy sinh. Vì vậy:
- Tuyệt đối không rửa bình dưới ao hồ
- Không để nước rửa trôi thuốc sau phun chảy trực tiếp vào nguồn nước
- Không xem nhẹ khâu xử lý nước thải sau pha thuốc
Nguyên tắc ứng dụng thực chiến tại vườn
Luân phiên đúng nhóm cơ chế tác động
Đây là nguyên tắc số một. Nhiều nhà vườn nghĩ rằng đổi từ Abamectin sang Emamectin benzoate là đã luân phiên thuốc. Thực ra không phải vậy. Hai hoạt chất này vẫn nằm trong cùng một hướng cơ chế tác động. Nếu dịch hại đã giảm nhạy với một bên, đổi sang bên kia thường không tạo ra khác biệt đủ lớn.
Muốn luân phiên đúng, cần chuyển sang nhóm khác thật sự, ví dụ:
- Với nhện đỏ có thể luân phiên sang nhóm chuyên trị nhện khác
- Với sâu miệng nhai có thể chuyển sang nhóm Diamides hoặc Indoxacarb tùy tình huống
- Với bọ trĩ có thể xoay sang nhóm khác có cơ chế tác động khác biệt
Điều cốt lõi là luân phiên theo nhóm cơ chế, không luân phiên theo tên thương mại.
Tận dụng đúng khả năng thấm sâu
Với Abamectin hoặc Emamectin, khả năng thấm sâu là một ưu thế rất lớn, nhưng để khai thác được tối đa thì kỹ thuật phun phải tốt. Trong thực tế, nên lưu ý:
- Phun khi lá khô
- Ưu tiên thời điểm mát để giảm mất hoạt chất ngoài bề mặt
- Bảo đảm phủ đều vùng lá mục tiêu
- Với lá dày sáp, có thể cần hỗ trợ bằng chất loang trải hoặc chất phụ trợ phù hợp
Tuy nhiên, không nên lạm dụng phụ trợ quá mạnh vì có thể làm tăng nguy cơ nóng lá hoặc gây phản ứng không mong muốn trên mô non.
Không dùng theo phản xạ chỉ vì thuốc “quen tay”
Đây là lỗi rất phổ biến. Vì thuốc gốc kháng sinh cho hiệu quả rõ trên nhiều đối tượng khó trị, nhiều nhà vườn có xu hướng mặc định dùng lại hoạt chất cũ mỗi khi thấy nhện đỏ, bọ trĩ hoặc sâu nhỏ xuất hiện.
Cách làm đó rất nguy hiểm về lâu dài. Muốn giữ giá trị của nhóm thuốc này, cần xem nó là một phần trong cả chiến lược quản lý dịch hại, chứ không phải là giải pháp duy nhất cho mọi lứa sâu hại.
Kết luận
Thuốc trừ sâu gốc kháng sinh là một trong những thành tựu rất quan trọng của bảo vệ thực vật hiện đại. Nhóm này cho thấy sự giao thoa rất rõ giữa sinh học và hóa học: nguồn gốc đến từ quá trình lên men vi sinh, nhưng hiệu lực ngoài thực tế lại mạnh, rõ và đủ sức giải quyết nhiều đối tượng khó trị mà các nhóm thuốc khác xử lý chưa thật tốt.
Giá trị lớn nhất của nhóm thuốc này nằm ở ba điểm:
- Hiệu lực rất cao ở liều thấp
- Có khả năng xử lý tốt các đối tượng nhỏ, sống khuất như nhện đỏ, bọ trĩ, dòi đục lá
- Phù hợp với nhiều chương trình canh tác cần kiểm soát tốt dư lượng
Tuy nhiên, đây cũng là nhóm đòi hỏi kỷ luật sử dụng rất cao. Muốn dùng hiệu quả lâu dài, người làm kỹ thuật cần ghi nhớ:
- Không lạm dụng một hoạt chất quen thuộc qua nhiều lứa
- Không nhầm lẫn giữa đổi tên thuốc và đổi nhóm cơ chế
- Không xem nhẹ rủi ro với ong và thủy sinh vật
Khi hiểu đúng như vậy, thuốc trừ sâu gốc kháng sinh sẽ được đặt đúng vai trò của nó: một công cụ rất mạnh, rất giá trị, nhưng chỉ thật sự bền vững khi được dùng có chiến lược.

 Hotline: 0338 220 522 – 0976 109 504
Hotline: 0338 220 522 – 0976 109 504 Địa chỉ: Số 651 – 653 Điện Biên Phủ, Phường Thạnh Mỹ Tây, Thành phố Hồ Chí Minh, Việt Nam
Địa chỉ: Số 651 – 653 Điện Biên Phủ, Phường Thạnh Mỹ Tây, Thành phố Hồ Chí Minh, Việt NamKênh Youtube: Kỹ thuật trồng cây – KTTC
Kết nối qua Facebook Fanpage tại: Duli Agri và Kiến Thức Nông Nghiệp – KTTC
Theo dõi kênh Tiktok tại: Kỹ Thuật Trồng Cây – KTTC

Kênh Youtube:
Kênh Youtube:
Pingback: Thuốc trừ sâu: Khái niệm, phân loại và nguyên tắc sử dụng an toàn trong nông nghiệp | Kỹ Thuật Trồng Cây